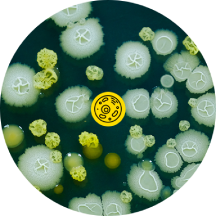

|
|
Обратный звонок |
НАСЕКОМЫХ ГРЫЗУНОВ ИНФЕКЦИЙ СОРНЯКОВ
ЗАПАХОВ
ЛИДЕРЫ ЗАКАЗОВ
На сайте указана минимальная (базовая) стоимость выполнения работ, которая может быть изменена после консультации со специалистом в большую сторону для надлежащего выполнения услуги!
ВЫЕЗД ПО НСО

Выезд: по НСО 15 руб/км

ПРОВОДИМ ОБРАБОТКУ В ПОМЕЩЕНИЯХ ЛЮБОГО ТИПА
 |
 |
 |
 |
 |
 |
||||
|
КВАРТИРЫ ЧАСТНЫЕ ДОМА КОТТЕДЖИ |
|
УК УПРАВЛЯЮЩИЕ КОМПАНИИ ОБЩЕЖИТИЯ |
|
ОФИСЫ МАГАЗИНЫ СУПЕРМАРКЕТЫ КАФЕ |
ПРОИЗВОДСТВЕННЫЕ КОМПАНИИ СКЛАДСКИЕ ПОМЕЩЕНИЯ |
|
УЧЕБНЫЕ ЗАВЕДЕНИЯ ДЕТСКИЕ САДЫ, ШКОЛЫ |
ЛИЦЕНЗИЯ • ДОГОВОР • РАССРОЧКА
ДЛЯ ФИЗИЧЕСКИХ ЛИЦ • РАБОТА
С ОРГАНИЗАЦИЯМИ • ТЕНДЕР
НАШИ ПРЕИМУЩЕСТВА
 |
 |
 |
 |
 |
| ПРОФЕССИОНАЛИЗМ | МЫ РЯДОМ | БЕЗОПАСНОСТЬ | ГАРАНТИЯ | РАБОТАЕМ ДЛЯ ВАС |
|
Поэтому выполняем работу быстро и качественно |
Дезинфектор в каждом районе |
Выполняем работы по нормам СНИП
|
Гарантируем результат 100% |
Уже несколько лет на рынке. Подбираем удобное время для клиента |
СЕРТИФИКАТЫ
 |
 |
 |
 |
 |
||||
 |
 |
ДЕЗИНФЕКТОРЫ
 |
 |
 |
Александр
|
Роман
|
Анна
|
|
|
|
|
|
НСО |
р.п. Линёво |
г. Куйбышев |
|
г. Бердск г. Искитим г. Черепаново г. Маслянино г. Сузун НСО |
г. Барабинск |
НОВОСТИ КОМПАНИИ
Новости Все
-
С 07 февраля 2025 года«Благополучие РФ»обладает лицензией на деятельностьпо оказанию услуг по дезинфекции, по дезинсекции и дератизации
-
Очередное обучение в Феврале 2024 дезинфектора в Москве. Получен сертификат...
-
В феврале 2024 обучение дезинфектора А. В. Гордеева в Москве...
БЕСПЛАТНАЯ КОНСУЛЬТАЦИЯ ДЕЗИНФЕКТОРА
Вас проконсультирует опытный дезинфектор:
 |
 |
||||||||||||||||||||||||
 |
+7 913-926-25-68 | ||||||||||||||||||||||||
| +7 923-151-29-53 | |||||||||||||||||||||||||
| Пн-Вс: с 09:00 до 21:00 | |||||||||||||||||||||||||
|
ЗВОНИТЕ! |
Дезинфектор3 разрядаАндрей ВладимировичГордеев | ||||||||||||||||||||||||
| Предоставляем: удостоверение, паспорт, лицензию,чек! | |||||||||||||||||||||||||